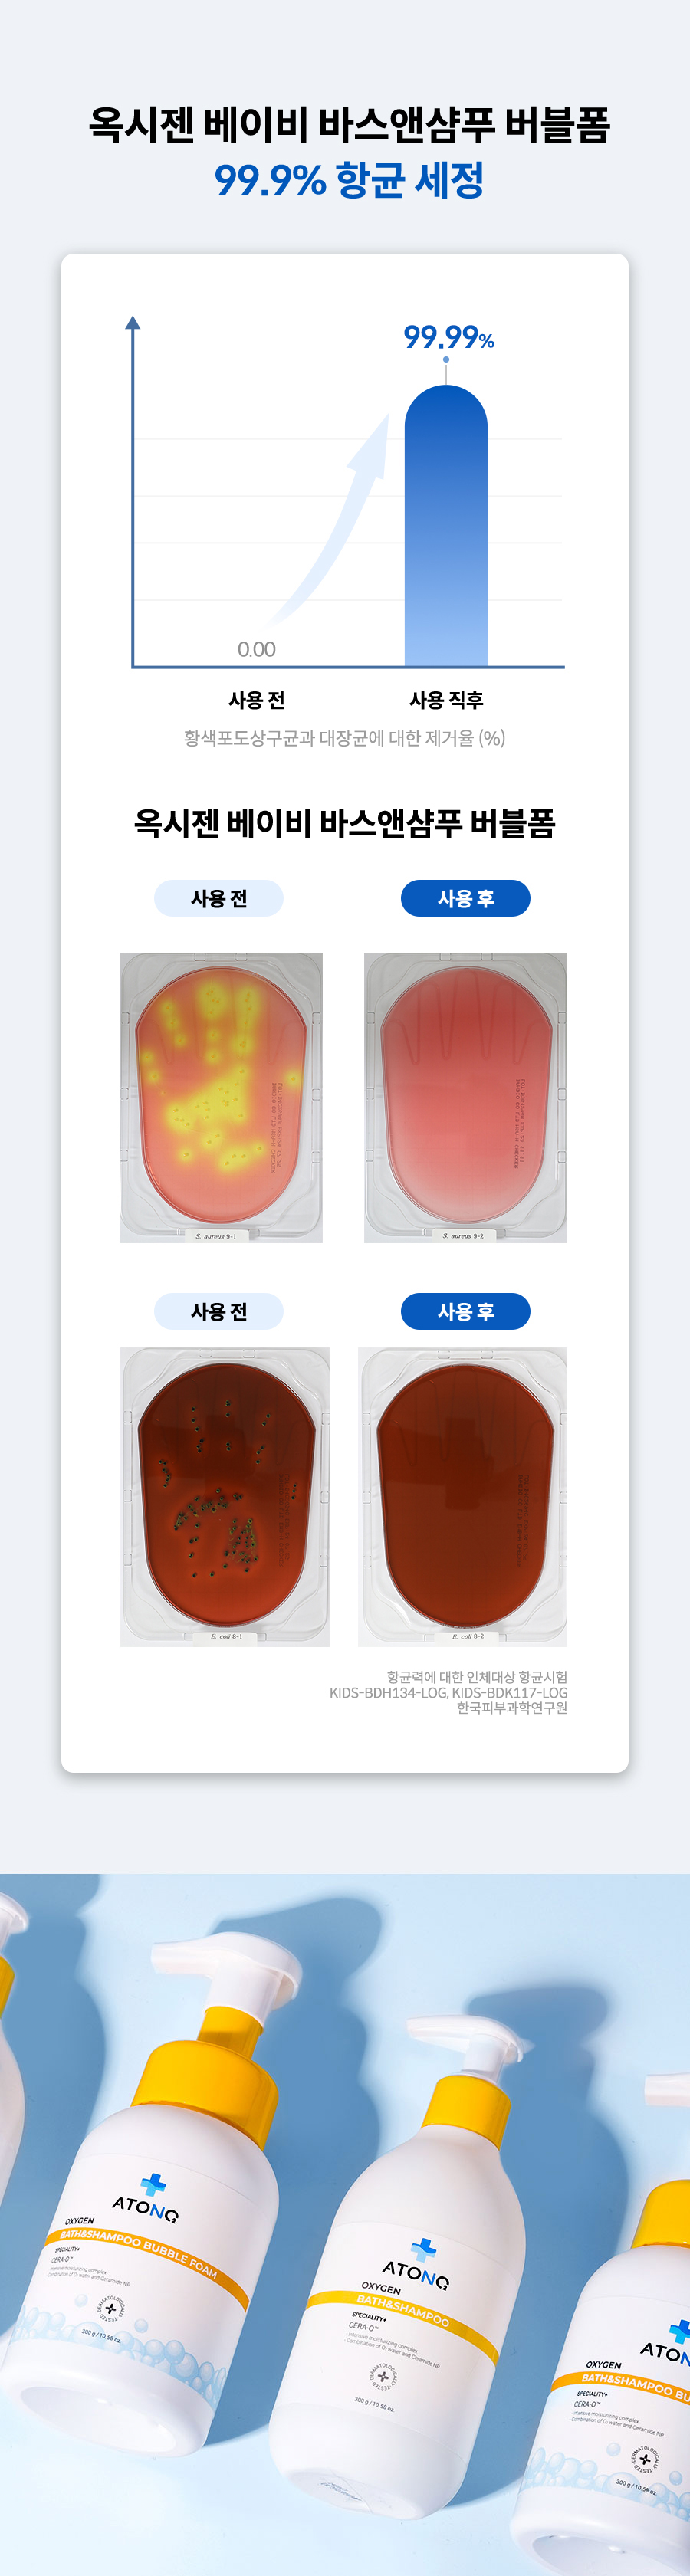

찜 완료 목록보기
찜 취소
- 여성브랜드의류
- 여성트랜드의류
- 유니섹스 캐주얼
- 남성의류
- 남성정장/셔츠
- 언더웨어
- 스포츠패션/슈즈
- 골프패션/클럽
- 등산/캠핑/자동차
- 헬스/자전거/수영/스키
- 패션잡화
- 패션슈즈
- 수입명품/해외배송
- 시계/보석/쥬얼리
- 명품화장품
- 화장품/향수
- 헤어/바디/미용기기
- 임신/출산/기저귀/분유
- 유모차/카시트/가구/매트
- 유아동의류/잡화
- 유아동도서/완구/교구
- 신선식품
- 즉석/가공식품
- 음료/커피/간식
- 건강식품/홍삼
- 다이어트식품
- 세제/화장지/생리대
- 생활/청소/수납
- 주방
- 건강/다이어트/실버
- 문구/악기/도서/취미
- 거실가구
- 침실가구
- 학생/아동/주방수납
- 침구/커튼/카페트
- 홈데코/인테리어소품
- 리모델링/시공/DIY
- TV/냉장고/세탁기/계절가전
- 주방/생활/이미용가전
- 카메라/캠코더/드론
- 휴대폰/음향/차량용기기
- 컴퓨터/주변기기/게임
- 여행/숙박/항공권
- 상품권/이용권
- 렌탈/배달/케어
- 보험/금융
- 반려동물
- 해외배송
- 패션플러스
- 벨리곰
[아토앤오투] 옥시젠 세라오 바스앤샴푸 버블폼 2개
배송비 3,000원 (30,000원 이상 무료) 배송비절약
추가 배송비 별도 (도서산간 3,000원, 제주 3,000원)
사이즈 추천을 위해 고객님의 키/몸무게를 입력해 주세요.
고객님께서 입력한 사이즈를 기반으로 적합한 사이즈를 찾을 수 있습니다.
- 키
- 몸무게
키/몸무게 정보를 저장하시면 다음에는 키/몸무게 입력없이 사이즈 추천이 가능합니다.
저장된 키/몸무게는 마이롯데에서 변경하실 수 있습니다.
저장된 키/몸무게 정보로 사이즈 추천 서비스를 제공하기 위해 고객님의
동의가 필요합니다.
| 수집하는 자 | 롯데홈쇼핑 |
|---|---|
| 수집항목 | 신체정보(신장,체중) |
| 수집목적 | 사이즈 추천 서비스 제공 |
| 보유 및 이용기간 | 서비스 종료 시까지 |
선물하기로 마음을 전해보세요. i
상세정보
- 상품코드 3263305365

구매/배송정보
![[아토앤오투][아토앤오투] 옥시젠 세라오 바스앤샴푸 버블폼 2개](https://image2.lotteimall.com/goods/65/53/30/3263305365_S.jpg)
[아토앤오투][아토앤오투] 옥시젠 세라오 바스앤샴푸 버블폼 2개
45,900 원
| 청구할인가 | 5만원↑ 구매 시 5% 청구할인 (삼성카드) |
|---|---|
| 포인트 | 엘포인트 45P |
| 배송정보 |
택배
30,000원 이상 무료배송 / 배송비 3,000원
배송비절약
|
| 교환/반품정보 |
반품비 3,000원
(도서산간 3,000원, 제주 3,000원 추가 반품비 별도) 반품정보안내 |
본 상품의 필수정보 및 인증정보
| 내용물의 용량 또는 중량 | 300g |
|---|---|
| 제품 주요 사양 | 상세페이지참조 |
| 사용기한 또는 개봉 후 사용 기간 | 개봉 전 36개월 / 개봉 후 12개월 |
| 사용방법 | 피부세정이 필요한 부위에 1-2회 펌핑하여 거품을 덜어냅니다. 부드럽게 마사지하듯 세정하여 미온수로 깨끗이 헹구어 줍니다. 필요에 따라 샤워볼과 함께 사용합니다. |
| 화장품제조업자 / 화장품책임판매업자 / 맞춤형화장품판매업자 | (주)라오가닉 |
| 제조자 / 수입여부 | 아마란스 / 해당없음 |
| 제조국 | 한국 |
| 화장품법에 따라 기재·표시하여야 하는 모든 성분 | 상세페이지참조 |
| 화장품법에 따른 기능성 화장품의 경우 화장품법에 따른 기능성 화장품 심사(또는 보고)를 필함의 문구 | 화장품법에 따른 기능성 화장품 심사(또는 보고)를 필함. 해당없음 |
| 사용할 때의 주의사항 | 상세페이지 참고 |
| 품질보증기준 | 공정거래위원회 고시 '소비자 분쟁해결 기준'에 의해 보상받을 수 있습니다. |
| 소비자상담 관련 전화번호 | 1800-1077 |
| 표시광고주체 | 주식회사 라오가닉 |
| 소재지(주소) | 서울 강남구 테헤란로78길14-13, 8층 (대치동 891-49, 포스타빌딩) |
| 연락처 | 010-3202-2674 |
배송/결제/반품정보
상품의 공급방법 및 시기- 배송소요 기간은 주문입금일(무통장 입금은 입금확인일) 익일을 기산일로 하여 일반상품은 2~7일, 설치 및 주문제작상품은 5~15일 (최장30일)이 소요됩니다. 다만, 일부 상품의 경우 배송지역 등의 사정으로 기간이 초과될 수 있으며, 이에 대해서는 별도로 고객님께 통지(안내전화 등)하여 드립니다. 단, 공휴일, 천재지변에의 경우, 배송소요 기간에서 제외됩니다.
- 주문하신 상품 또는 용역의 품절 등으로 제공 불가 시에는 그에 필요한 조치를 취하고 그 사유를 고객님께 통지합니다.
배송 및 교환/반품 안내
주의사항: 상품특성(설치상품, 상품크기, 일부 저단가 상품 등) 또는 지역여건(산간, 도서지역)에 따라 배송이 지연되거나 추가 배송비가 발생할 수 있습니다.
- 일부 유료 교환/반품 상품의 경우, 상품의 불량이 아닌 고객의 변심/주문오류로 인한 교환/반품 시 회수비용을 고객께서 부담하셔야 합니다.
- 반품 회수 비용은 기존 결제금액에서 차감한 비용을 환불해 드리는것이 원칙이나, 결제수단 및 주문유형에 따라 추가 결제 등 일부 상이할 수 있습니다.
- 협력사에서 직접 방문설치 및 시공하는 상품의 경우 배송 지역 및 상황에 따라, 교환/반품 회수 비용이 추가로 부과될 수 있으므로 사전에 상품에 표기된 상세 정보를 반드시 확인해 주시기 바랍니다.
스마트픽 : 온라인에서 주문하고 오프라인에서 픽업할수 있는 서비스입니다.
세븐일레븐 편의점 및 하이마트로 주문 시 상품 도착일로부터 5일 동안 지정하신 지점에서 픽업 가능하며, 기간 내 미수령 시 자동반품 됩니다.
배송 및 교환/반품비용
| 배송비 | 교환/반품비 |
|---|---|
|
30,000원 이상 조건부 무료배송 / 배송비:3,000원
(추가 배송비 : 도서산간 3,000원, 제주 3,000원) |
단순변심, 착오구매로 인한 반품 신청시 3,000원을 부담해야 하는 상품입니다. (경우에 따라 왕복비용으로 인한 반품비 6,000원 및 도서산간 추가 비용이 발생할 수 있습니다.) |
청약철회 청구안내
상품을 인도받은 날로부터 아래 교환/반품/환불 유의사항 제1호의 기간 및 비용 부담 기준에 따라 당해 계약에 관한 청약을 철회할 수 있습니다. (사전 및 별도 고지된 일부 상품 제외)
청약철회는 '마이롯데'에서 직접 접수하시거나, 1:1문의 혹은 1899-4000으로 접수 가능합니다.
교환/반품/환불 유의사항
1. 구매하신 상품의 교환/반품 가능 기간 및 교환/반품비 부담 기준은 다음과 같습니다.
| 교환/반품사유 | 교환/반품 가능기간 | 교환/반품비 부담 |
|---|---|---|
| 구매자의 단순 변심, 착오구매 | 상품수령 후 7일 이내 | 구매자 부담 |
| 상품의 하자, 오배송 | 상품수령 후 3개월 이내, 혹은 그 사실을 알 수 있었던 날로부터 30일 이내 | 무료 (판매자 부담) |
※ 상품에 따라 신청에 제한이 있을 수 있으며, 상품페이지에 표시된 기간이 7일보다 긴 경우 그 기간이 적용됩니다.
※ 경우에 따라 왕복비용으로 인한 반품비가 발생할 수 있습니다. (예, 배송비 3000원일 경우 왕복배송비 6000원 청구)
2. 다음의 경우에는 교환/반품요청 가능기간에도 불구하고 반품이 거절될 수 있습니다.
- 이용자에게 책임 있는 사유로 재화 등이 멸실 또는 훼손된 경우(다만, 재화 등의 내용을 확인하기 위하여 포장 등을 훼손한 경우에는 청약철회를 할 수 있습니다)
- 이용자의 사용 또는 일부 소비에 의하여 재화 등의 가치가 현저히 감소한 경우
- 시간의 경과에 의하여 재판매가 곤란할 정도로 재화 등의 가치가 현저히 감소한 경우
- 같은 성능을 지닌 재화 등으로 복제가 가능한 경우 그 원본인 재화 등의 포장을 훼손한 경우
- 이용자의 주문에 따라 개별적으로 생산된 재화 또는 이와 유사한 재화 등의 경우
- 용역 또는 「문화산업진흥 기본법」 제2조제5호의 디지털콘텐츠의 제공이 개시된 경우. 다만, 가분적 용역 또는 가분적 디지털콘텐츠로 구성된 계약의 경우에는 제공이 개시되지 아니한 부분 제외
- 냉장/냉동/생물 등의 신선식품인 경우 상품 특성상 배송준비가 시작된 후
3. 반품시에는 반드시 택배사가 발행하는 운송장을 환불시까지 보관하여야 하며, 운송장은 반품 사실의 입증자료입니다.
4. 환불은 물류센터의 반품도착 확인 후 3영업일 이내에 진행되며, 환급 지연 시에는 지연기간에 대하여 관련 법령에 따라 지연이자를 지급합니다. 단, 신용카드로 결제 시 매출 취소 시점까지의 이자를 추가 지급하지 않습니다.
5. 반품운송장에 기재된 상품/사은품/수량만을 반품하여야 하며, 수량/구성품이 부족한 경우에는 환불되지 않고 반송 처리될 수 있습니다. 반품운송장에 기재되지 않은 물건을 반품하거나, 반품 신청이 되지 않은 상품을 택배사에 인도한 경우에는 회사가 책임을 지지 않습니다.
6. 교환/반품/환불에 따라 고객님이 추가로 부담하여야 할 사항이 있는 경우에는 그 내용과 금액에 대해서 상품 주문 시 또는 교환/반품/환불 접수 및 진행 시 별도 안내하도록 합니다.
전자상거래 소비자보호에 관한 법률에 의한 반품규정이 상품공급업체가 지정한 반품조건보다 우선합니다. [자세히보기]
소비자피해보상, 분쟁 처리에 관한 사항
본 상품에 대한 품질보증 및 피해보상에 관한 사항은 소비자피해 보상규정 소비자분쟁해결기준(공정거래위원회 고시 2015-18호)에 의거 합니다. 회사와 발생한 분쟁이 원만히 처리되지 않은 경우, 한국소비자원 www.kca.go.kr/02-3460-3000을 통하여 피해구제를 신청할 수 있습니다.
결제대금예치에 관한 사항
회사는 고객님께서 현금으로 결제하신 금액에 대하여 기업은행과 채무지급보증계약을 체결하여 안전거래를 보장하고 있습니다.
당일 4시간 이내에 배송해드립니다.
(서울 전 지역/ 오전10시~오후 5시 30분까지 주문시)
- 주문 금액에 따른 바로배송비가 부과됩니다.
10만원 이상 5,000원 / 10만원 미만 10,000원 - 롯데백화점의 같은 지점 상품만 주문이 가능합니다.
- 상품상세화면에서 바로배송 가능상품을 확인하신 후,
주문서에서 ‘픽업서비스로 받기/ 배송방법 변경’을
선택해주세요. - 교환/반품시에는 일반 택배만 가능합니다.
- 오후 5시 30분 이후부터 자정 내 주문 시, 다음 날 오후 2시 내 배송됩니다.
- 자정 이후 부터 오전 10시 내 주문 시, 당일 오후 2시 내 배송됩니다.
- 백화점 휴일 전날 오후 5시 30분 이후 주문은 불가합니다.
- 주문마감 시간 이전 주문시 당일발송
(상품 별 주문마감 시간 상이) - 상품도착은 택배사 사정에 따라 1~2일 소요
- 다른상품과 함께 주문 시 당일발송 상품에서 제외
리뷰
고객님께서 기존에 등록하신 피부타입/고민 저장 서비스의 제공 목적이 아래와
같이 확대되었습니다. 내용 확인 후 동의 여부를 체크해 주시기 바랍니다.
개인정보 수집 및 이용 동의
| 수집항목 | 출생년도, 성별, 피부타입, 피부고민 |
|---|---|
| 수집목적 | 맞춤 상품평 및 상품 추천 서비스 제공, 상품평과 함께 공개되어 다른 고객의 상품구매에 도움을 주는 서비스에 활용 |
| 보유 및 이용기간 | 서비스 종료 시 및 동의 철회 시까지 |
- 이에 동의하지 않으실 수 있으나, 동의하지 않으실 경우에는 맞춤 상품평 및 상품 추천 서비스를 제공 받으실 수 없습니다.
Q&A
- 롯데카드 3~6,10개월
- 하나카드 10개월
- 그 외 신용카드: 카드사별 상이 (최대 3개월)
- 5만원 이상 결제시 적용가능
- 결제승인일기준, 행사기간 동안 할부조건에 따라 무이자 할부 가능
- 무이자혜택은 함께 구매하시는 다른 상품의 무이자 할부 개월 수에 따라 달라질 수 있음
- 일시불할인금액은 주문서 작성시 사용하시는 할인혜택에 따라 다시 계산되므로 현재 보이는 금액과 다를 수 있음
- 최대 무이자 할부개월수 및 결제 기준금액 상이할 수 있음
- 삼성카드 2개월 무이자 할부 불가
- 할부개월수는 상품별로 상이 (일부상품 제외)
- 청구/즉시할인 한도 초과 시 혜택 적용이 제한될 수 있습니다. (행사·카드사별 기준 상이, 자세한 내용은 혜택 안내 페이지 참고)
찜 완료 목록보기
찜 취소
담기완료 목록보기
쿠폰발급
완료





![[아토앤오투][아토앤오투] 옥시젠 세라오 바스앤샴푸 버블폼 2개](https://image2.lotteimall.com/goods/65/53/30/3263305365_L.jpg)

상품 구매 후 첫번째 후기를 작성해보세요.